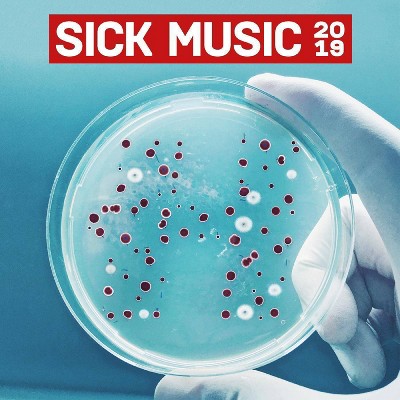
VARIOUS ARTISTS - Sick Music 2019 (CD)

Various - Anthology Of Noise/Electronic Music 2 (CD)

Store: Target
Last Price: 19.99 USD
Similar Products
Products of same category from the store
AllProduct info
undefined
Price History
Cheapest price in the interval: 19.99 on October 28, 2021
Most expensive price in the interval: 19.99 on November 6, 2021
Price Archive shows prices from various stores, lets you see history and find the cheapest. There is no actual sale on the website. For all support, inquiry and suggestion messages communication@pricearchive.us

![Jay-Z - Magna Carta Holy Grail [Explicit Lyrics] (CD)](https://target.scene7.com/is/image/Target/GUEST_d35dbc34-a0ae-4217-abf3-d6af281c9eae)

![Icon - Sublime [Explicit Lyrics] (CD)](https://target.scene7.com/is/image/Target/GUEST_ebce4d2f-178a-4ddf-832d-eaa283b84bfe)

